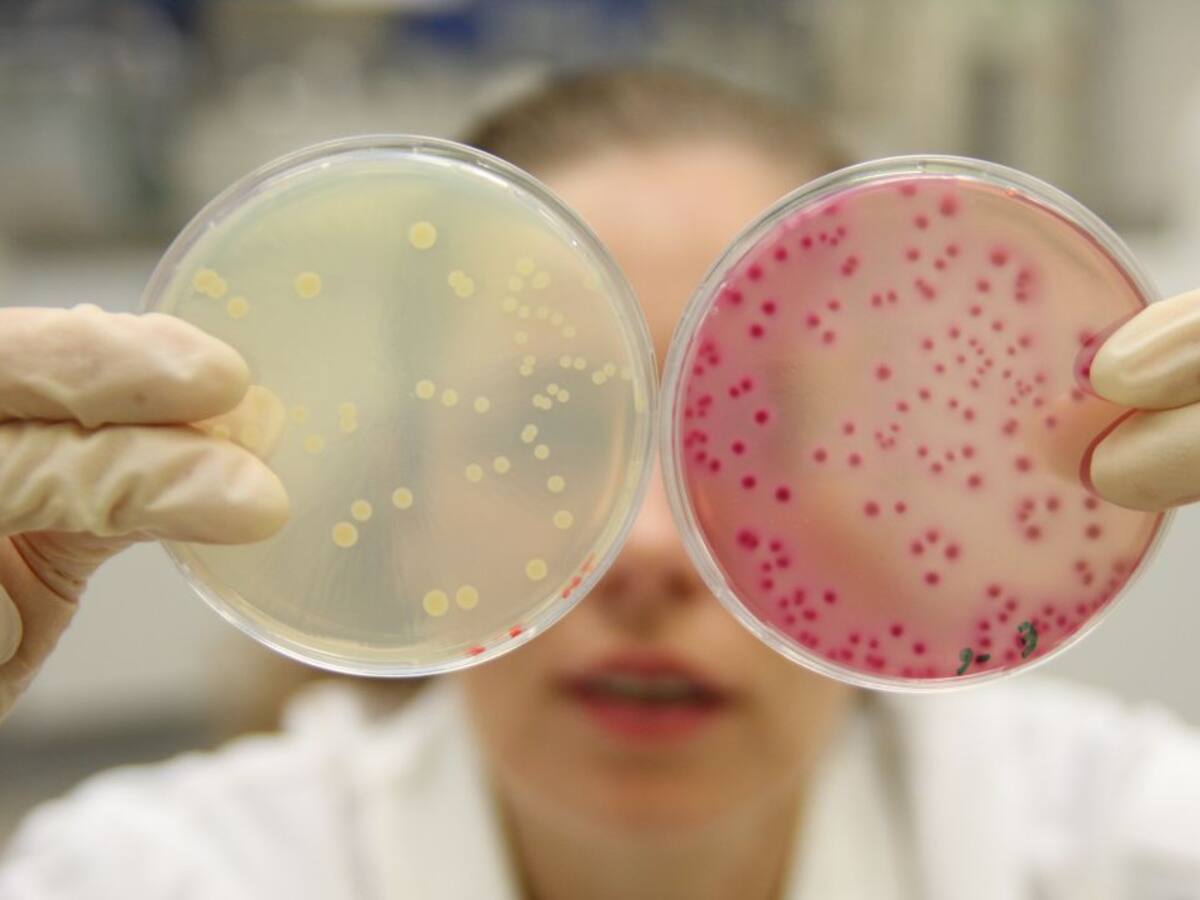
Financiación estable para los Institutos de investigación de la Universidad

Entre la antigüedad del profesorado y la necesidad de incorporar jóvenes
El rector de la Universidad de Zaragoza pide que el Gobierno de Aragón asuma parte de los costes de personal del campus público
31/03/2019 - 18:58
Pepe Lasmarías
Zaragoza
Selecciona tu emisora

El rector de la Universidad de Zaragoza pide que el Gobierno de Aragón asuma parte de los costes de personal del campus público
31/03/2019 - 18:58
Pepe Lasmarías
Zaragoza

27/03/2019 - 12:33
Mónica Farré
Zaragoza

18/03/2019 - 16:36
Pilar García Atienza
Zaragoza

11/03/2019 - 14:36
Mónica Farré
Zaragoza

11/03/2019 - 12:24
Esther Orera
Zaragoza

07/03/2019 - 16:25
Pilar García Atienza
Zaragoza

06/03/2019 - 14:40
Pilar García Atienza
Zaragoza

27/02/2019 - 12:01
EFE
Teruel

22/02/2019 - 17:50
Pilar García Atienza
Zaragoza

21/02/2019 - 11:42
Pilar García Atienza
Zaragoza

14/02/2019 - 12:53
Lorena Ruano | Esther Orera
Zaragoza

11/02/2019 - 13:47
Juanjo Hernández | Mónica Farré
Zaragoza

10/02/2019 - 18:43
Ana Sánchez Borroy
Zaragoza

16/01/2019 - 14:33
Juanjo Hernández | Mónica Farré
Zaragoza

13/01/2019 - 13:04
Pilar García Atienza
Zaragoza

03/12/2018 - 16:49
Pilar García Atienza
Zaragoza

27/11/2018 - 12:51
Lorena Ruano
Zaragoza
21/11/2018 - 12:07
Pilar García Atienza
Zaragoza

15/10/2018 - 13:11
Pilar García Atienza
Zaragoza

19/09/2018 - 14:34
Pilar García Atienza
Zaragoza

17/09/2018 - 14:21
Pepe Lasmarías
Zaragoza

16/09/2018 - 11:17
P. García | Mónica Farré
Zaragoza

22/08/2018 - 12:53
Pilar García Atienza
Zaragoza

09/08/2018 - 14:30
Mónica Farré
Zaragoza

23/07/2018 - 12:39
Esther Orera
Zaragoza

26/06/2018 - 12:46
Pilar García Atienza
Zaragoza

22/06/2018 - 14:48
Esther Orera
Zaragoza

13/06/2018 - 19:03
Pilar García Atienza
Zaragoza

12/06/2018 - 15:54
Pilar García Atienza
Zaragoza

05/06/2018 - 12:46
Pilar García Atienza
Zaragoza

04/06/2018 - 12:31
Pilar García Atienza
Zaragoza

28/05/2018 - 13:02
Pilar García Atienza

24/05/2018 - 13:02
Pepe Lasmarías
Zaragoza

23/05/2018 - 12:42
Pilar García Atienza
Zaragoza

14/05/2018 - 14:28
Pilar García Atienza
Zaragoza

10/05/2018 - 14:32
Esther Orera
Zaragoza

08/05/2018 - 17:23
Mónica Farré
Zaragoza

26/04/2018 - 14:27
Mónica Farré
Zaragoza

23/04/2018 - 14:45
Esther Orera
Zaragoza

18/04/2018 - 20:06
Rosa Royo
Zaragoza
Ahora en directo
Cadena SER
00:00 - 23:59
00:00 - 23:59
Otros directosCadena SER
00:00 - 23:59
Podcast
Síguenos en
Otros episodios
Cualquier tiempo pasado fue anterior
Tu audio se ha acabado.
Te redirigiremos al directo.
5 "